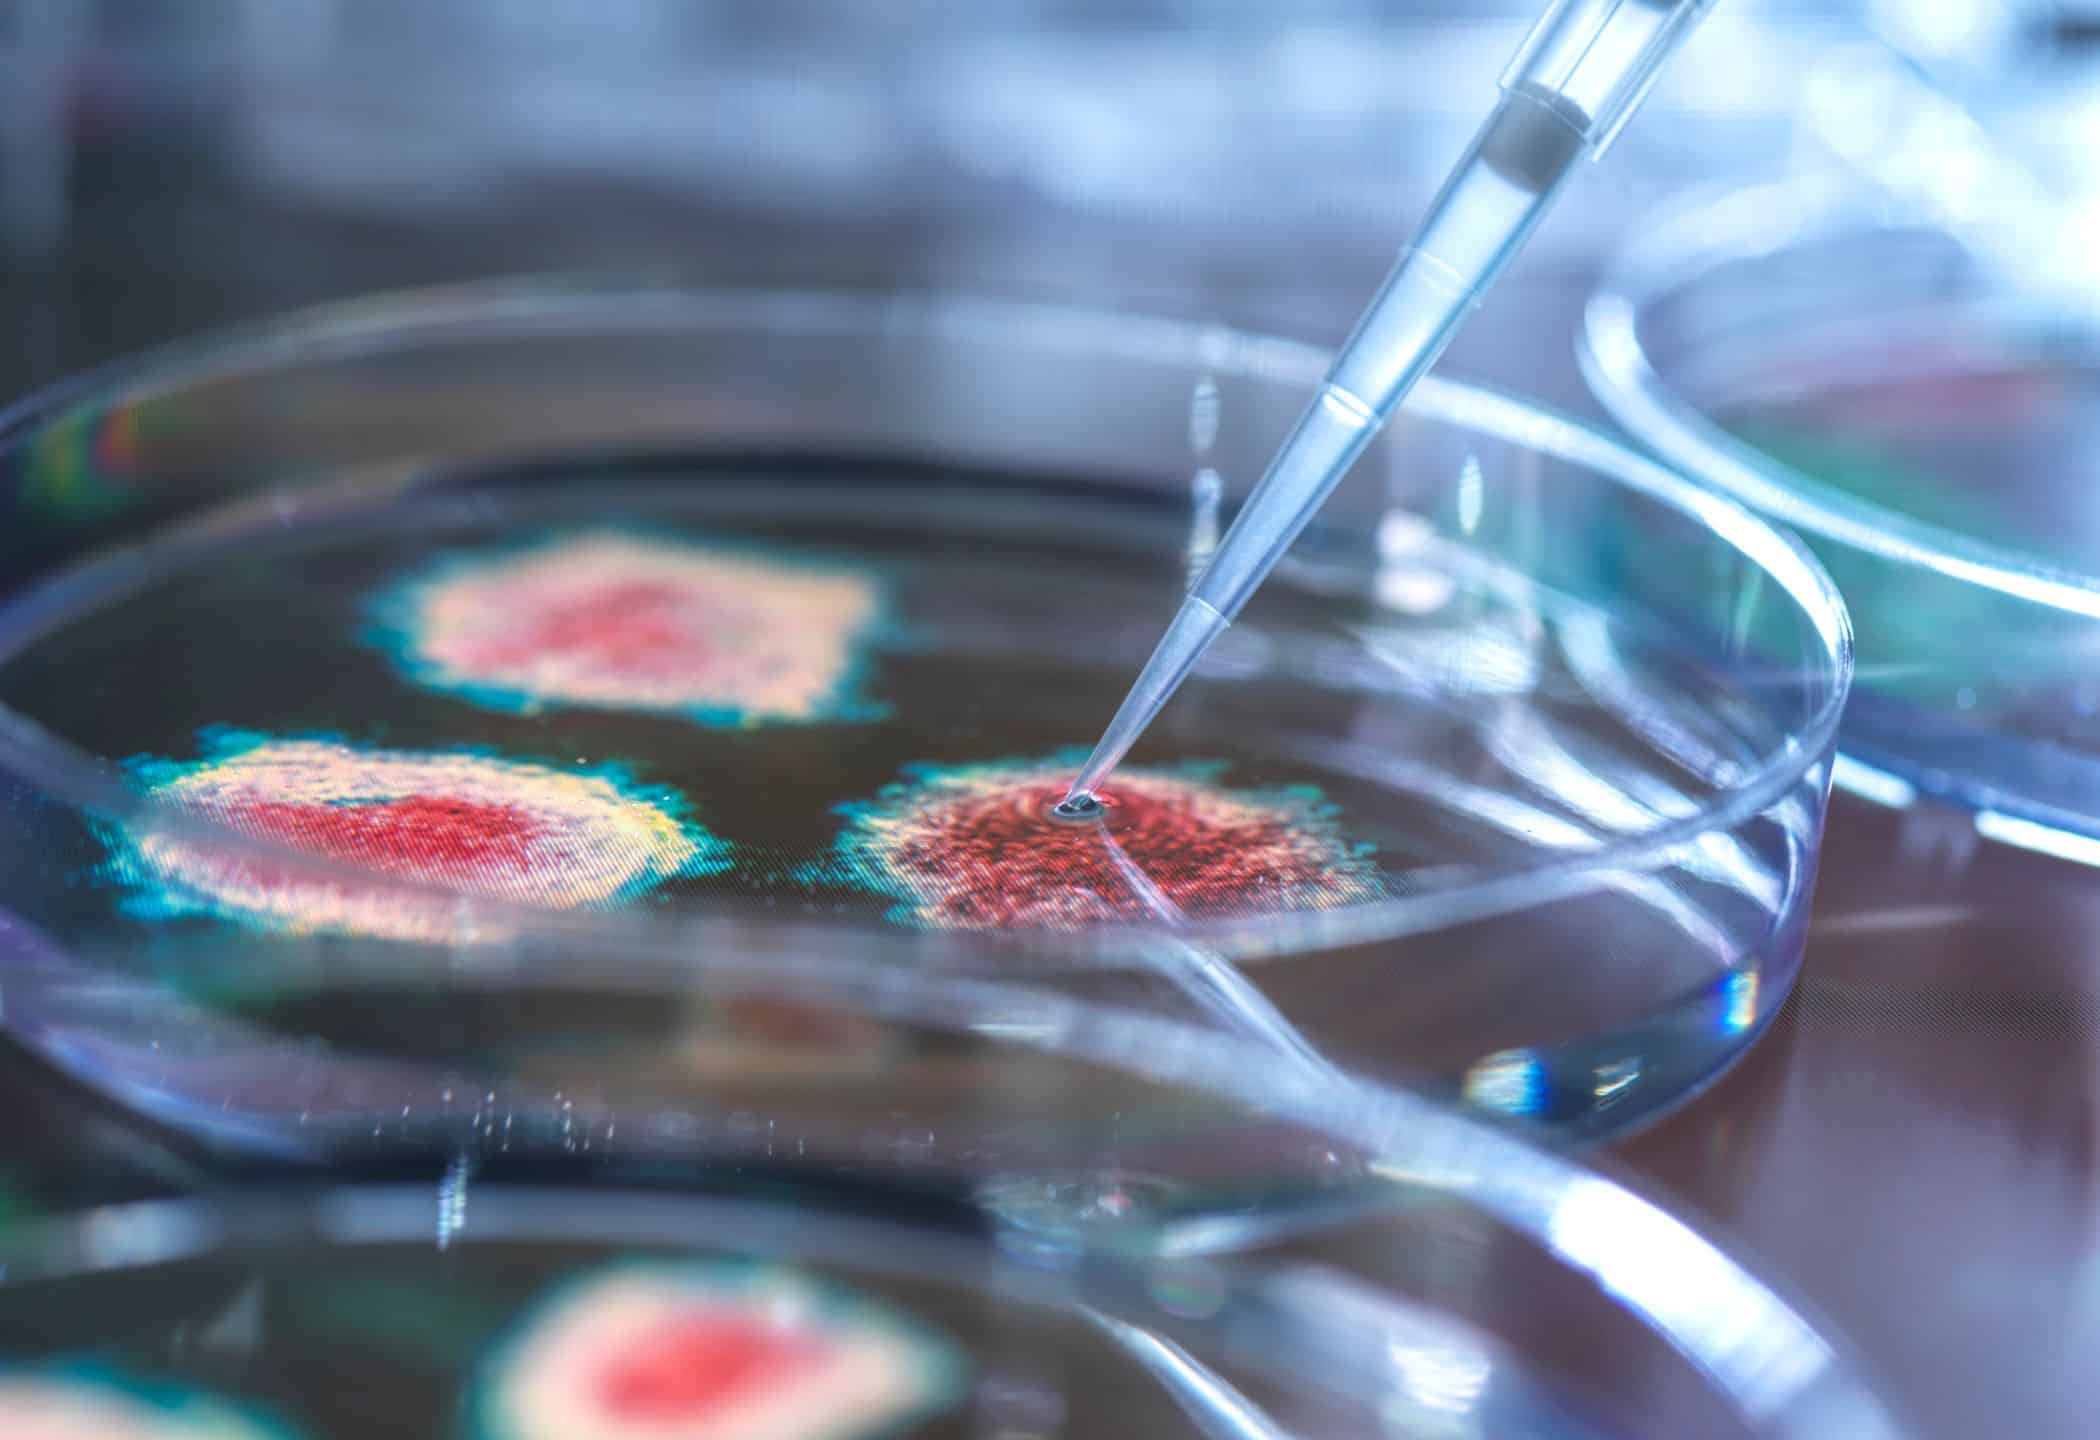

Dit wil je weten over het Marburg virus
4 oktober 2024
In Rwanda zijn zes mensen overleden aan het marburgvirus. Twintig anderen zijn er ook mee besmet sinds de uitbraak. Wat is het Marburg virus?
Het marburgvirus is een zeldzaam, maar zeer besmettelijk en dodelijk virus. De kans op overlijden is bijna negentig procent. Het gaat gepaard met plotselinge koorts, hoofdpijn, overgeven, spierpijn en buikpijn. In een later stadium volgen hevige bloedingen en vallen organen uit.
Het Marburg-virus is een filovirus, dat ontdekt werd in 1967 toen er gelijktijdige uitbraken waren in Marburg en Frankfurt (Duitsland), en in Belgrado (Servië). Deze uitbraken werden veroorzaakt door Afrikaanse apen (groene apen) die uit Oeganda werden ingevoerd voor onderzoek.
De natuurlijke gastheer van het Marburg-virus zijn waarschijnlijk vruchtenetende vleermuizen, met name de Egyptische grootoorvleermuis (Rousettus aegyptiacus). Het virus kan worden overgedragen van vleermuizen op mensen en vervolgens van mens tot mens.
Marburg lijkt op ebola en wordt door besmette vleermuizen overgedragen op mensen. Mensen kunnen elkaar besmetten via lichaamsvloeistoffen als bloed en speeksel. Het is voor het eerst dat het virus in Rwanda opduikt.
Geen vaccin
De besmette mensen zijn in quarantaine geplaatst en worden behandeld. Mensen die met de patiënten in aanraking zijn geweest, worden in de gaten gehouden. Dat zijn er tot nu toe ruim honderdzestig.
Hoe kun je een besmetting met het marburgvirus voorkomen?
Reis je in een gebied waar het marburgvirus voorkomt, vermijd dan:
- contact met fruitvleermuizen of bezoek aan grotten of mijnen waarin zij kunnen wonen,
- contact met primaten (mensapen),
- contact met mensen met klachten zoals koorts, spierpijn of huiduitslag, contact met bloed of andere lichaamsvloeistoffen.
Lees ook: 5 vragen die de huisarts vaak stelt
Tekst Manon Daelmans
Beeld Getty Images
Bron: Nos.nl
Uit andere media






